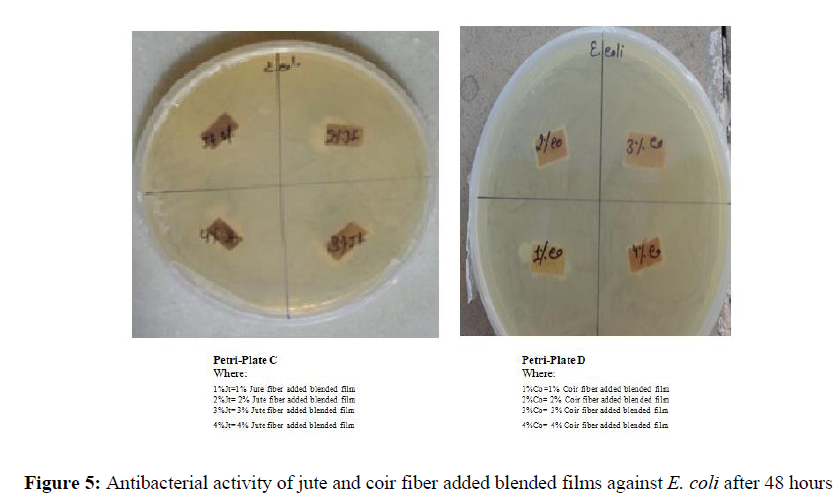
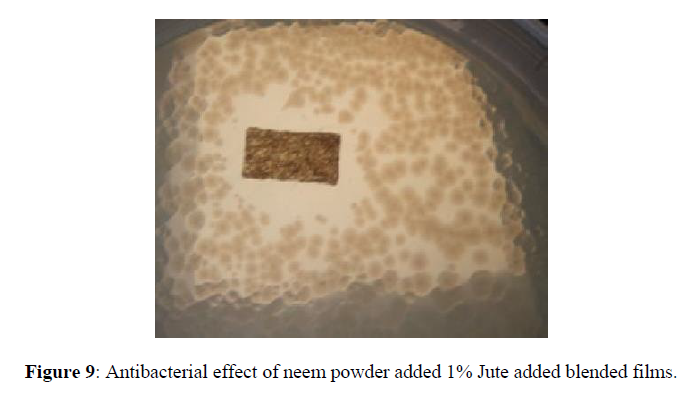

Research Article - Der Pharma Chemica ( 2022) Volume 14, Issue 7
Exploring the Antibacterial Activity of Jute and Coir Fiber added Chitosan-Starch blended Films
Neena Singh and Jaya Maitra*Jaya Maitra, Department of Applied Chemistry, School of Vocational Studies and Applied Sciences, Gautam Buddha University, Greater Noida, India, Email: maitra.jaya@gmail.com
Received: 05-Jul-2022, Manuscript No. dpc-22-68529; Editor assigned: 07-Jul-2022, Pre QC No. dpc-22-68529; Reviewed: 21-Jul-2022, QC No. dpc-22-68529; Revised: 23-Jul-2022, Manuscript No. dpc-22-68529; Published: 30-Jul-2022, DOI: 10.4172/0975-413X.14.7.21-28
Abstract
This work aims at antibacterial testing of calcium chloride cross-linked starch and chitosan (50:50) biodegradable blended films. The blended films are incorporated with 1%, 2%, 3% and 4% of two different natural fibers, Jute and coir. The prepared blended films are subjected to test the antibacterial property against Escherichia coli.
No bacterial growth on the surface of jute and coir fiber added blended films are found. Besides, one attention-grabbing thin line (hair like) of zone of inhibition is observed around 1% jute fiber added blended film. Furthermore, to boost the antibacterial effect of jute and coir blended films, 2 gm of dry Azadirachta indica (neem) leaf powder is added to each 50 gm of the starch-chitosan blend containing 1% jute fiber and 1% coir fiber. The antibacterial property of blended films is observed after 24 hours. Zone of inhibition for neem leaf powder added 1% jute fiber blended film get extended to 18 to 20 mm while microbial growth is not observed on the surface of Azadirachta indica leaf powder added 1% coir fiber blended film. All the results are observed under microscope Nikon Eclipse Ti 60 X.
Keywords
Blend; Chitosan; Crosslinking; Jute; Coir; Neem leaf powder
INTRODUCTION
The non-biodegradable (prepared from synthetic polymers) polymeric materials and packaging films applied in the biomedical field and food packaging, cause serious ecological problems. The major apprehensions of consumers for environmental protection show the way to increase research towards the biodegradable polymeric materials [1,2]. Owing to environmental concerns including sensitivity and responsiveness the natural polysaccharides may possibly emerge as a potent alternative of biodegradable polymeric materials. Natural polysaccharides get degraded without leaving behind ecologically harmful residues [3].
The local natural polysaccharides utilized in preparation of polymeric material for biomedical relevance and food packaging films are either derived from animals’ body or from plants material. The main natural polymers derived from animals are collagen, elastin, keratin, silk, chitin and chitosan while natural polymers derivatives of plant material are starch, cellulose and pectin [4].
Natural polymers, collagen and elastin derived from animal sources are insoluble in water and organic solvents; however, extracted collagen from the tissue of young animals is soluble in dilute acetic acid [4]. The processing of silk, elastin and keratin is further problematic because of their highly insoluble nature, but hydroxylation supports the solubility of these natural polymers. Chitosan is soluble in dilute acetic acid but the resulting concentration may be low to a certain extent. It depends on the molecular weight of the natural polymer [4].
The collagen and chitosan solubility in acetic acid recommend these polysaccharides to blend them with other water soluble polymers [4,5]. The most abundance of chitosan (after cellulose) makes it the most accomplished polymer for blending rather than collagen [6,7]. Chitosan is attained by the deacetylation of chitin. Chitin is the most important constituent of crustacean’s cuticles i.e. crabs, prawns, shrimps and lobsters. Chitin is also found in cell walls of some fungi such as aspergillus and mucor [8]. Chitin is inelastic, white and hard nitrogenous polysaccharide. It is the most important resource of pollution in coastal areas. Chitin is a straight chain homopolymer consisting of -(1,4)-linked N-acetyl-glucosamine units while chitosan is a co-polymers of glucosamine and N-acetyl-glucosamine [6, 9,10]. 70% deacetylated chitosan is achieved by the deacetylation of chitin in 40% sodium hydroxide at 120 for 1–3 hour [11]. At least 50 % deacetylated form of chitin become soluble in dilute acetic acid solution (pH < 6.5), which can convert the glucosamine units into R–NH3+ which make it soluble and is known as chitosan [4,12]. In alkaline solutions or with polyanions it gets precipitates and forms gel at lower pH [10]. Chitosan has excellent film-forming ability. Chitosan is suitable for obtaining antimicrobial films [13], as cationic film forming agent in skin care products [14] and for food coating and packaging [13,15]. Commercially, chitosan is accessible in the form of powder, dry flakes and solution. Commercially available form of chitosan is generally 60 to 100% deacetylated and it has an average molecular weight ranging between 300 to 1000 kDA [16, 17]. The structures of chitin and chitosan are shown in Figure 1 and Figure 2.
In the present study, chitosan (animal derived polymer) was blended with water soluble the next most abundant natural polysaccharide: starch (plant derived polymer). Starch is a carbohydrate, a source of energy store in plants. During the process of photosynthesis a friction of carbon fixed in chloroplasts is retained as starch [18]. Low cost renewability and complete biodegradability of starch shows potential for developing sustainable materials [19, 20]. Semi-crystalline polymer, starch is composed of two polymers with D-glucose repeating units i.e. amylose and amylopectin. In fact amylose is a linear polymer consisting of α [1-4] linked glucose moieties, whereas amylopectin is quite complicated, it is highly branched molecule with α [1-6] branching linkages [21]. Different proportions of amylose and amylopectin depends on the source /origin, weather and growing conditions of the plant [22]. Starch stores in plant in a granular form. Heating with water reveals the complex nature of granules. The chains contained by the granules itinerant and the disruption start between the hydrogen bonding of the adjacent glucose units meanwhile water penetrates the matrix [23]. Transparent and brittle molded articles prepared from starch and water, is found sensitive to the atmospheric moisture [24]. Starch is poor in process ability, and also in the dimensional stability and mechanical properties for its end products [25-27]. Inclusion of the other polysaccharides through blending or by cross linking enhance the mechanical properties of starch films [28]. Blending of two or more polymers is a well-established strategy to attain precise combination of physical properties [29]. Furthermore, it is an efficient way to prepare compatible materials. Starch blended films with different polymers are widely investigated and the films obtained from chitosan and starch, is recommended for medical applications and food packaging [30]. Starch granules increase the water vapor permeability of the films, which allowed it to “breath” and make it more comfortable for food packaging [31].
Antimicrobial property of completely biodegradable blended films proposes the better-quality packaging material for biomedical application and food safety, quality and environmental concern. Antimicrobial packaging systems limit or prevent the microbial growth by increasing the lag period or by reducing the growth rate of microorganisms [32]. Chitosan and starch (50:50) blended biodegradables and edible films have already been tested earlier as economical material for antimicrobial packaging. These films proved to be effective against two bacteria i.e. Salmonella enterica and Escherichia coli [30]. But films encounter certain problems such as brittle nature, poor mechanical strength and high solubility.
Owing to the above mentioned problems, the blended films cannot be used as a packaging material either for food packaging or biomedical purpose. Food packaging specifically depends on the form of food (liquid, semidry, dry), accordingly the packaging material choose for packing/wrapping/casing. Food packaging also depends on the direct or indirect application of packing material on the surface of food. The main utility of packaging material is to provide protection and preservation to the food from the external contamination which may include the safety and quality of packaged food, retardation of deterioration and extension of shelf life [2].
In this paper, to overcome the above mentioned problems i.e. to give the mechanical strength and to retard the brittle nature and solubility of the films, two different processed natural fibers (jute and coir) are added to the blended films and the antibacterial property of the prepared blended films are to be tested against E. coli.
MATERIALS AND METHODS
Polymers and Reagents
Chitosan from Himedia, Starch, extra pure from Titan Biotech Ltd., Calcium-chloride from Himedia, Acetic acid glacial, free aldehyde.A.R. From Himedia, Parafilm “M” from Pechiney Plastic Packaging Chicago, Jute fabric from Mechanical Laboratory Gautam Buddha University, Greater Noida (U.P.), India. Coconut fiber (coir) from vender in Kasana (Gr. Noida, India), Neem leaves from neem plants in Gautam Buddha University Campus.
Treatment of fibers
Treatment of Jute fiber
Jute fabric is to cut into the pieces and dipped in 6% NaOH solution for 72 hours then washed several times under normal running water and then 12 to 15 times with distills water. Having dried the fiber pieces at 1500C in oven for 6 to 7 hours, it is to be grinded with mixer and sieve the fiber with 60BSS sieve.
Treatment of Coir fiber
Coir fiber is to cut into the small pieces and dip in 20% NaOH solution and then place in oven for 2 hours at 80ºC. Treated fiber is then to be neutralized with same concentration of HCl solution. Further having dipped in 20% NaOH solution for another 2 hours and again it is to be placed in oven at 80ºC. Then the resulting fiber is to be thoroughly crushed with piston mortar. Subsequently fiber is to be washed thoroughly under the tap water and afterward distill water. The resulting fiber is to be dried in oven at 80ºC for 6 hours and then at 120ºC for 3 hours. Finally, after drying the fiber, it is to be grinded with mixer and sieved with 60BSS sieve.
Preparation of Azadirachta indica (Neem) leaf powder
Fresh Azadirachta indica leaves are collected from neem plants in Gautam Buddha University Campus and dried at room temperature. After drying, Neem leaves are grinded with mixer and sieved with 60BSS sieve.
Preparation of Chitosan-Starch blend (cross-linked with Calcium-chloride)
Chitosan solution (2% (w/v)) is prepared by dissolving 2 gm of chitosan in 100ml of 1% acetic acid aqueous solution. Having done this the solution is placed under stirring for at least 24 hours at 600rpm. After stirring solution is allowed to settle down for the next 24 hours at room temperature. 2% (w/v) starch solution is also prepared by dissolving 2 gm of starch in 1% acetic acid aqueous solution at 85ºC. 100ml of starch solution is added to 100ml of chitosan solution with continuous stirring at 600rpm, then added 20ml of 2% (w/v) calcium chloride solution drop by drop into the resulting mixture. The mixture is finally subjected to stirrer for 24 hours at 500rpm. Now the blend of starch-chitosan is ready for the next experiment.
Preparation of jute/coir fiber added blended films
The resulting blend weighing 100gms is added with 1gms, 2gms, 3gms and 4gms sieved fiber and then placed under continuous stirring for at least 24 hours. After that, the blends are poured in the petri-plates and kept at room temperature for drying. After drying, thin films are peeled off from the petri-plates and are placed in hot air oven at 25-30ºC for 15 minutes. Having done this it is to be placed at room temperature. Then the resulting thin films are stored in plastic poly bags.
Preparation of Azadirachta indica (Neem) leaf powder added blended films
2.0 gm of neem leaf powder is added to 50gm of 1% jute/1% coir fibers containing starch-chitosan blend and stirrer the blend for next six hour. Then the mixture is poured in petri-plates and kept at room temperature for drying.
Assay of antibacterial activity
Luria-Bertani (LB) agar petriplates are prepared by dissolving the 2.5 gm LB-broth and 3gm Agar in 100ml distill water to test the antibacterial property of the blended against E. coli. 20 μl of overnight grown culture of bacteria is spreaded on two different 90 x 15 mm size of petriplates named as A and B. All the films are cut into 1/2x1 cm in size and place to the petriplates accordingly. 1/2x1 cm of 1%, 2%, 3% and 4% jute fiber added films are placed in petriplate A while 1/2x1 cm of 1%, 2%, 3% and 4% coir fiber added films are placed in petriplate B. Petriplates are placed at 37ºC in incubator and placed under observation for 24 hours and 48 hours. Same experiment is repeated with 2gm Neem leaf powder added 1% jute/coir fiber blended films against E. coli.
RESULTS AND DISCUSSION
Antibacterial activity of films against E. coli after 24 hours for jute fiber added blended films (Figure 3)
Only the 1% jute fiber added blend is showing thin hair line zone of inhibition in comparison to the 2%, 3% and 4% jute fiber added blended films. As the ratio of the added fiber to the blend increases the brittleness of the film decreases and but no microbial growth was observed after 24 hours in the near vicinity of the blended films with the increase in percentage jute fiber.
Antibacterial activity of films against E. coli after 24 hours for coir fiber added blended films (Figure 4)
The brittleness of the films improved with the addition of coir fiber in the blended films and no zone of inhibition was seen in the blended films added with coir fiber after 24 hours of observation.
Antibacterial activity of films against E. coli after 48 hours for jute and coir fiber added blended films (Figure 5)
After 48 hrs, both jute as well as coir fiber added blended films showed improvement in their mechanical property as well as anti-bacterial activity against E. coli [Table 1 & Table 2] [Figure 3].
| Petriplate | Sample | Brittleness | Zone of inhibition(mm) |
|---|---|---|---|
| >C | 1% Jute fiber added | Very brittle | 1.0 mm |
| C | 2% Jute fiber added | Brittle | 1.2mm |
| C | 3% Jute fiber added | Less brittle | 1.3mm |
| C | 4% Jute fiber added | Same as 3% | 1.4m |
| Petriplate | Sample | Brittleness | Zone of inhibition(mm) |
|---|---|---|---|
| >D | 1% Coir fiber added | Very brittle | 1.0 mm |
| D | 2% Coir fiber added | Brittle | 1.2mm |
| D | 3% Coir fiber added | Less brittle | 1.2mm |
| D | 4% Coir fiber added | Not brittle and foldable | 1.3m |
Jute and coir fiber added blended films are peeled off carefully from both the petri-plates A and B and the bacterial growth is observed under microscope Nikon Eclipse Ti 60 X. The pictures taken from the microscope showed no bacterial growth on the surfaces of the films, after 24 hours. [Figures 6-8].
Antibacterial effect of dried Azadirachta indica (neem) leaf powder added to 1% Jute and 1% Coir fiber blended films
An enhanced of zone of inhibition for of 18 to 20 mm was observed for dried Azadirachta indica leaf powder added in 1% jute fiber added blended films after 24 hrs. But no zone of inhibition was observed in case of coir fiber added blended films after 24 hours even after addition of Azadirachta indica leaf powder [observed by inverted microscope Nikon Eclipse (Figures 9,10).
CONCLUSION
The present research focuses on the progress of natural fiber added starch-chitosan blended film. The immensely important feature such as low cost, biodegradability, renewability and easy availability of jute and coir fibers, represented a promising research work to enhance the mechanical property of the blended films. Chitosan present in the blended film also provided antimicrobial property, but as the ratio of fibers to the blended films is increased, films were not showing zone of inhibition after 24 hours. Only 1% jute fiber added film showed the very thin zone of inhibition after 24 hours. After 48 hours all the fiber added films were showing zone of inhibition. In this attempt to enhance the antimicrobial property dried Azadirachta indica leaf powder was added to 1% jute and coir fiber added starch-chitosan blended films and an enhanced zone of inhibition was observed after 24 hours in case of 1% jute fiber added film while no microbial growth is observed on the surface of Azadirachta indica leaf powder added 1% coir fiber added film after 24 hours. Addition of natural fibers to the blended film not only significantly improved the brittleness of the films, but also incorporated antibacterial property. Lots of scope is there to improve the antimicrobial property of the blended film. If used in combination with medicinal plant extract, these blended films could be made more antimicrobial .This research work will be very helpful to the scientific community to develop such a novel economic, biodegradable and non-toxic product which can be used as a valuable material for packaging industry as well as in biomedical field such as wound healing.
Conflicts of interest
There are no conflicts of interest.
References
- Fajardo P, Martins JT, Fuciños C, et al., J Food Eng. 2010, 101: p. 349-356.
- Pawar PA, Aachal, Purwar H. Am J Eng Res. 2013, 2(5): p. 151-164.
- Simkovic I. Carbohydrate Polymers. 2013, 95: p. 697-715.
- Sionkowska A. Prog Polym Sci. 2011, 36: p. 1254-1276.
- Sionkowska A, Wisniewski M, Skopinska J, et al., Biomaterials. 2004, 25: p. 795-801.
- Rinaudo M. Prog Polym Sci. 2006, 31: p. 603-632.
- Dutta PK, Dutta J, Tripathi VS. J Sci Ind Res. 2004, 63: p. 20-31.
- Sinha VR, Singla AK, Wadhawan S, et al., Int J Pharm. 2004, 274: p. 1-33.
- Singla AK, Chawla M. J Pharm Pharmacol. 2001, 53: p. 1047-1067.
- Kato Y, Onishi H, Machida Y. Curr Pharm Biotechnol. 2003, 4: p. 303-309.
- Bahrami SB, Kordestani SS, Mirzadeh H. Iran Polym J. 2003, 12(2): p. 139-146.
- Chandy T, Sharma CP. Artif Cells Artif Organs. 1990, 18: p. 1-24.
- Dutta PK, Tripathi S, Mehrotra GK, et al., Food Chemistry. 2009, 114 (4): p. 1173-1182.
- Savary G, Grisel M, Picard C. Natural Polymers: Industry techniques and applications. 2016, p. 219-262.
- Niamsa N, Baimark Y. Am J Food Technol. 2009, 4: p. 162-169.
- Liu X, Ma L, Mao Z, et al., Adv Polym Sci. 2011, p. 81-127.
- Croisier F, Jerome C. Eur Polym J. 2013, 49(4): p. 780-792.
- Zeeman SC, Kossmann J, Smith AM. Annu Rev Plant Biol. 2010, 61: p. 209-234.
- Zhang JF, Sun XZ. Biomacromolecules. 2004, 5: p. 1446-1451.
- Araújo MA, Cunha A, Mota M. Biomaterials. 2004, 25: p. 2687-2693.
- Jaya M, Neena S. Adv Polym Technol. 2014.
- Hoover R. Carbohydrate Polymers. 2001, 45: p. 253-267.
- Rodriguez-Gonzalez FJ, Ramsay BA, Favis BD. Polymer. 2003, 44: p. 1517-1526.
- Jie R, Hongye F, Tianbin R, et al., Carbohydrate Polymer. 2009, 77: p. 576-582.
- Choi EJ, Kim CH, Park JK. Macromolecules. 1999, 32: p. 7402-7408.
- Lu DR, Xiao CM, Xu SJ. Express Polymer Letters. 2009, 3(6): p. 366-375.
- Shah N, Mewada RK, Mehta T. Chemical Engineering. 2016, 32(2): p. 265-270.
- Shjvetlana ZR, Galina AV. Glycoconjugate Journal. 2006, 23: p. 611-618.
- Imre B, Pukánszky B. Eur Polym J. 2013, 49: p. 1215-1233.
- Neena S, Jaya M. J App Chem. 2015, 8(4): p. 26-32.
- Buchanan RA, Weislogel OE, Russell CR, et al., Ind Eng Chem Prod Res Dev. 1968, 7: p. 155-158.
- Espitia PJP, Du WX, Bustillos RDJA. Food Hydrocolloids. 2014, 35: p. 287-296.
Indexed at, Google Scholar, Crossref
Indexed at, Google Scholar, Crossref
Indexed at, Google Scholar, Crossref
Indexed at, Google Scholar, Crossref
Indexed at, Google Scholar, Crossref
Indexed at, Google Scholar, Crossref
Indexed at, Google Scholar, Crossref
Indexed at, Google Scholar, Crossref
Indexed at, Google Scholar, Crossref
Indexed at, Google Scholar, Crossref
Indexed at Google Scholar, Crossref
Indexed at, Google Scholar, Crossref
Indexed at, Google Scholar, Crossref
Indexed at, Google Scholar, Crossref
Indexed at, Google Scholar, Crossref